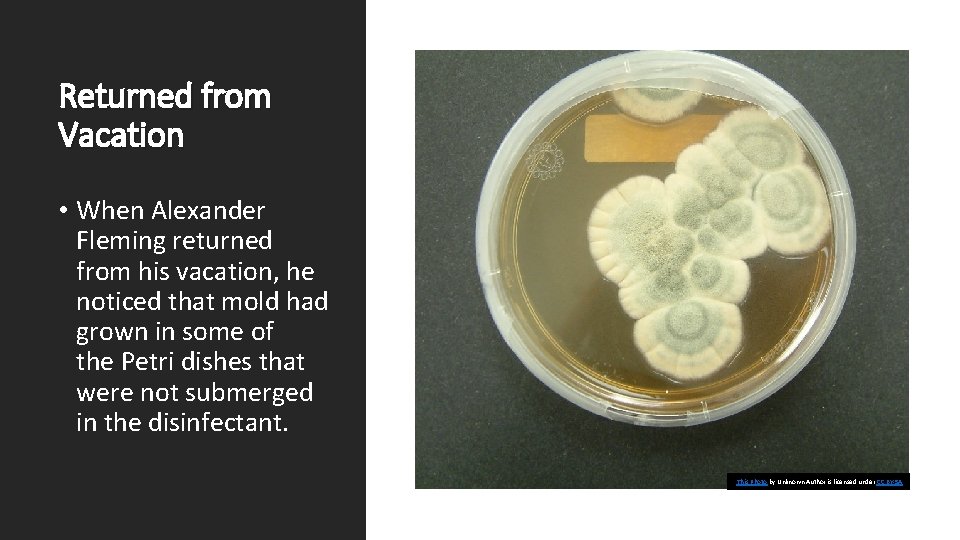
Returned from Vacation • When Alexander Fleming returned from his vacation, he noticed that
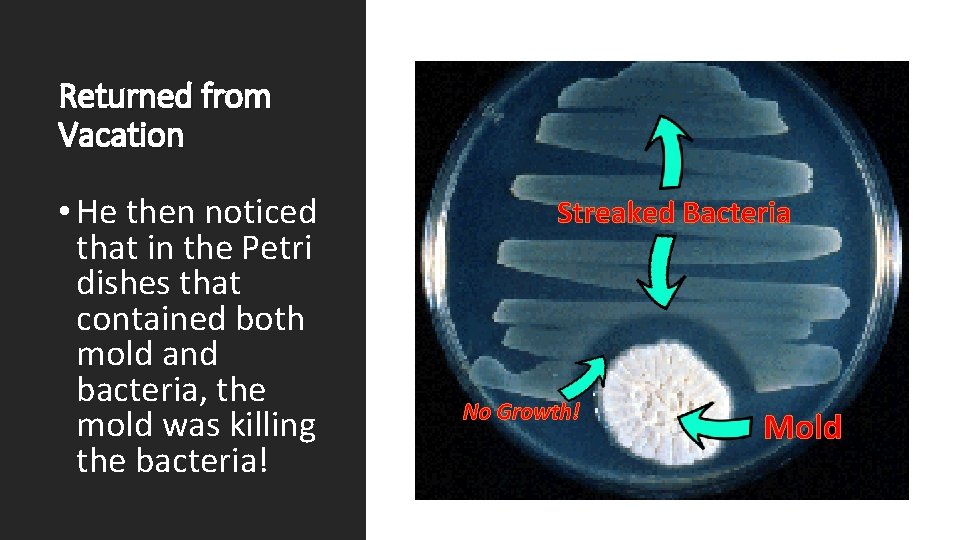
Returned from Vacation • He then noticed that in the Petri dishes that contained

Microbiology Study Guide Part I Subjects Covered Subject

Microbiology Study Guide Part I Subjects Covered: Subject I – Control of Bacterial Growth Subject II - Antibiotics

Antimicrobial Agents • A multi-million dollar industry has been created around the idea of keeping unwanted microorganisms from invading our homes and our bodies. • Any time you walk down the "cleaners" isle of your local grocery market, you are bombarded with products having words like "sanitizes", "disinfectant", and "antibacterial".

LET’S EXPLORE THE MEANING OF SOME OF THESE TERMS!

SANITIZATION • SANITIZATION - Sanitization is a process that reduces the microbial population to what is considered to be a "safe" level according to public health agencies.

SANITIZATION • The FDA sets regulations for what is considered “acceptable” amounts of feces, mold, bacteria, rodent hair, bug parts and larvae!

SANITIZATION • “the Food and Drug Administration (FDA) to establish maximum levels of natural or unavoidable defects in foods for human use that present no health hazard. ” www. fda. gov https: //www. fda. gov/Food/Guidance. Regulation/G uidance. Documents. Regulatory. Information/Sanitati on. Transportation/ucm 056174. htm White Fish - 50 parasitic cysts per 100 pounds (whole or fillets), provided that 20% of the fish examined are infested Fig Paste - Contains 13 or more insect heads per 100 grams of fig paste in each of 2 or more subsamples Peanut Butter - Average of 30 or more insect fragments per 100 grams Or Average of 1 or more rodent hairs per 100 grams Golden Raisins - 10 or more whole or equivalent insects and 35 Drosophila eggs per 8 oz.

STERILIZATION • - Sterilization is the complete destruction of any and all types of microorganisms. • Therefore, you can "sterilize" a counter top or a medical instrument, but you cannot "sterilize" living tissue. *It would be incorrect to say that the nurse had "sterilized" a wound, for example.

DISINFECTION • DISINFECTION - Disinfection refers to the destruction of pathogens (microorganisms that cause disease). • You can disinfect living or non -living surfaces.

Disinfectants vs Antiseptics • DISINFECTANT - This is used to disinfect non-living surfaces. A disinfectant is an antimicrobial agent that is used on a nonliving surface or object. • ANTISEPTIC - This is used to disinfect living surfaces. An antiseptic is an antimicrobial agent that is used on living tissue like the skin's surface. Antiseptics are used outside of the body. This Photo by Unknown Author is licensed under CC BY-NC-ND

Antibiotics vs Antiseptics • Antiseptics are antimicrobial agents that are used OUTSIDE the body. • Antibiotics are antimicrobial agents that are used INSIDE the body. Antiseptics Antibiotics Antiseptics are used On the OUTSIDE of the Body, while antibiotics are Used INSIDE the body. Antiseptics

Why Do We Want/Need to Control Microbial Growth? • In short, we must control the growth of microorganisms to prevent pathogens from reaching the body. This Photo by Unknown Author is licensed under CC BY-NC-ND

Methods of Controlling Microbial Growth • There are many different methods by which microorganism growth can be controlled. • The methods of microorganism growth control are grouped into 2 broad categories: 1. Physical methods 2. Chemical methods This Photo by Unknown Author is licensed under CC BY-SA

Physical Method #1 – Extreme Temperatures

Enzyme How Does Temperature Effect Microbial Growth?

Physical Methods • Physical Methods of Controlling Bacterial Growth Include… • Heat • Flame • Boil • Steam • Autoclave Heat Kills Some or All of the Microbes • Heat kills microbes by denaturing proteins. • Microbes with denatured proteins end up dead. This Photo by Unknown Author is licensed under CC BY-SA

Method of Growth Control - FLAMING • The easiest, most effective way to control microbial growth is to use a FLAME. • Common laboratory practice. • Heat kills microbes by denaturing proteins, which leads to death. This Photo by Unknown Author is licensed under CC BY-NC-SA

Method of Growth Control - BIOLING • BOILING - Will not kill bacterial spores, so may not be sterile. • Some species are thermophilic, so this method will not kill these microbes. This Photo by Unknown Author is licensed under CC BY-SA

Method of Growth Control AUTOCLAVING • AUTOCLAVE - Spores are killed with exposure to autoclave. • Autoclave achieves higher temperatures than boiling water. • Autoclaves use moist heat which causes protein denaturing.

Ovens (dry heat) vs. Autoclaves (moist heat) Ovens (dry heat) • Spores of a bacterium are eliminated using an autoclave in 15 min. • In a dry air oven, it takes two hours at 160°C to kill spores of the bacterium. Autoclaves (moist heat)

Refrigeration and Freezing to Control Growth • COLD - Refrigerator incubation slows down microbial growth, but does not kill microbes. • Freezing temperatures effectively halt microbial growth, but does not kill microbes. This Photo by Unknown Author is licensed under CC BY

Liquid Nitrogen is Used to Preserve Cells and Tissues Liquid nitrogen is usually between -210°C and -196°C or -346°F and -320. 44°F.

DEHYDRATION • - Taking water out of the environment will halt microbial growth. • This method is widely used in the preservation of foodstuffs. • Methods of dehydration include • sun-drying, like we see in dried fruits and beef jerky, • and the addition of salt or copious amount of sugar which draws water out using osmosis. • These foods are not sterile, but they are "preserved". This Photo by Unknown Author is licensed under CC BY-SA

Chemical Methods of Controlling Bacterial Growth Include…

Methods of Controlling Growth • IONIZING RADIATION – • UV light • Ionizing radiation forms free radicals which damages microbial DNA and proteins. • However, if the microbe is in the form of a spore, it may experience some protection from the effects of ionizing radiation.

ALCOHOL • ALCOHOL - ethyl alcohol (70%) and isopropyl alcohol (70%) or higher concentrations are great antimicrobial agents that are routinely used in hospitals and laboratories. • Ethyl alcohol kills bacteria through 2 mechanisms: 1. protein denaturation and 2. dissolving the lipid membrane.

Detergents • Detergents disrupt the lipid bilayer membranes of microorganisms. • Detergent monomers solubilize membrane proteins by partitioning into the membrane bilayer. • The detergents solubilize the membranes, the cytoplasm of the microorganism leaks out, and death follows. This Photo by Unknown Author is licensed under CC BY

Other Chemicals for Growth Control • FORMALIN, FORMALDEHYDE, GLUTERALDEHYDE - toxic, carcinogenic, but has good antimicrobial qualities. Commonly used for tissue preservation. • HALOGENS - These include bleach, chlorine, and iodine. • PEROXIDES - Releases free oxygen which leads to many chemical reactions in the microorganism that ultimately leads to death. This Photo by Unknown Author is licensed under CC BY-SA

Organic Matter Interferes with Antimicrobial Agents The presence of organic matter such as feces, urine or blood, reduces the effectiveness of antimicrobial agents by. . . • reacting with the antimicrobial agent so that none of the agent is available to kill the unwanted microorganism • physically coating the microorganism which provides a protective barrier between the microbe and the antimicrobial agent

• ANTIBIOTICS This Photo by Unknown Author is licensed under CC BY

Alexander Fleming in 1928 • The first antibiotic was discovered, quite by accident, by bacteriologist named Alexander Fleming in 1928. This Photo by Unknown Author is licensed under CC BY-NC-SA

• The first antibiotic was discovered, quite by accident, by bacteriologist named Alexander Fleming in 1928. • Alexander Fleming had been studying bacteria using Petri dishes. Alexander Fleming in 1928

Left for Vacation • Alexander left on vacation and left some unwashed Petri dishes piled high in a sink with Lysol. • Some of the dishes were submerged in the Lysol disinfectant and some were not, because they were located high on top of the dish pile.
Returned from Vacation • When Alexander Fleming returned from his vacation, he noticed that mold had grown in some of the Petri dishes that were not submerged in the disinfectant. This Photo by Unknown Author is licensed under CC BY-SA
Returned from Vacation • He then noticed that in the Petri dishes that contained both mold and bacteria, the mold was killing the bacteria! Streaked Bacteria No Growth! Mold

The Fungus Penicillium was the First Discovered Antibiotic • Alexander Fleming soon identified the mold to be the fungus Penicillium, which was later made available in the form of penicillin for medical use. This Photo by Unknown Author is licensed under CC BY-NC

This Photo by Unknown Author is licensed under CC BY-NC-ND ANTIBIOTICS TAKE CHARGE! • Since the discovery of penicillin, many more antibiotics have been discovered and manufactured. • These have a wide range of bacterial targets and a are able to combat bacterial growth through different means or "mechanisms of action".

What Are Antibiotics? • Antibiotics are simply defined as any drug that either kills or inhibits the growth (or reproduction) of one or more species of bacteria. This Photo by Unknown Author is licensed under CC BY

I just threw out the baby with the bath water! Selective Toxicity • An antibiotic or antimicrobial drug that exhibits "selective toxicity" will only kill or inhibit the growth of certain microbial targets, while leaving the host and nontargeted microbes alone. The old saying, “Don’t through out the baby with the bath water, ” means that you want to get rid of what you don’t want, but you want to keep what you do want.

Selective Toxicity • The way to achieve selective toxicity is to ensure that the target of the drug is only found in the organism that you want to kill and not in the host. This Photo by Unknown Author is licensed under CC BY-SA

Targets • A “target” is something that the antibiotic or antimicrobial will disrupt or destroy in order to kill or inhibit the growth of the microbe.

Selective Toxicity and Targets • Since humans are eukaryotic and bacteria are prokaryotic, there a lot of potential "targets" that bacteria have that humans don't.

Antimicrobials vs. Antibiotics • There are far fewer drugs (antimicrobials) available that target non-bacterial microbes like fungi, parasites, and viruses, because there are fewer unique targets to choose from.

Mechanism or Mode of Action • The “mechanism of action” or “mode of action” refers to HOW an antibiotic kills the bacteria. • There are 5 basic mechanisms of action that antibiotics use.


Bactericidal vs Bacteriostatic Antibiotics • Bactericidal Antibiotics will function Destroy or Kill Bacteria. • Bacteriostatic Antibiotics will function to stop or slow the growth of bacteria.

Antibiotic Range of Use Types of Bacteria The Major Categories of Antibiotics • Narrow-Spectrum Antibiotics - These antibiotics function to control the growth of only a narrow range of microorganisms. • Broad-Spectrum Antibiotics - These antibiotics function to control the growth of very large ranges of microorganisms.

PENICILLIN • Penicillin acts on the cell walls of Gram-positive bacteria. • They prevent peptidoglycans from forming. • Peptidoglycans are the major component of the cell wall, so without peptidoglycan, the cell wall cannot form. • This causes the bacterium to swell and burst.

• Gram negative bacteria have an outer membrane that prevents larger molecules like penicillin from entering the cell. This Photo by Unknown Author is licensed under CC BY-SA Methods of Antibiotic Resistance:

Antibiotic Resistance • Bacteria cells have been known to chemically alter binding proteins that the antibiotics recognize. • Some bacteria cells contain the enzyme betalactamase which hydrolyzes the antibiotic, rendering it useless.
- Slides: 49